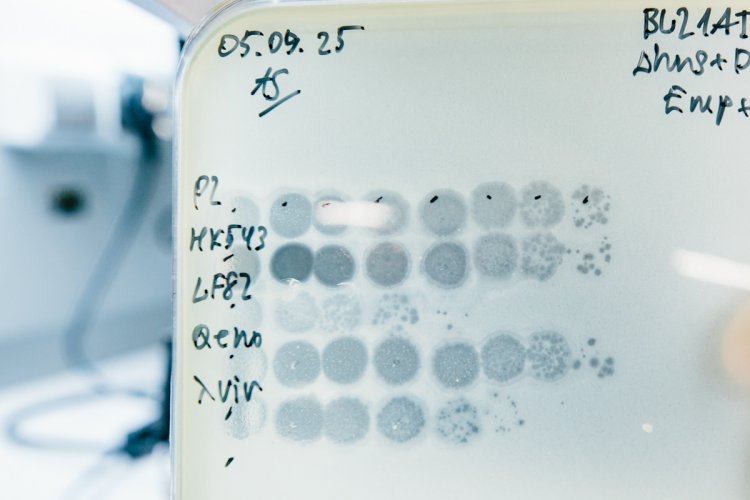

Чем могут быть полезны вирусы, способные заражать и убивать бактерий, ― бактериофаги? В чем особенность изучения подобных объектов и как работают иммунные системы их противников ― бактерий? Ученые лаборатории анализа метагеномов Сколтеха называют бактериофагов самой распространенной формой жизни на Земле и подчеркивают, что их взаимодействие с бактериями-хозяевами часто описывается в терминах «гонки вооружений». Подробнее об этом ― в нашем интервью со старшим преподавателем Сколтеха биологом Артемом Исаевым.
Справка: Артем Борисович Исаев ― кандидат биологических наук, старший преподаватель, руководитель лаборатории анализа метагеномов и заведующий лабораторией микробной иммунологии Центра молекулярной и клеточной биологии Сколтеха, руководитель проекта РНФ «Принципы распознавания вирусной инфекции абортивными системами противовирусного иммунитета бактерий».
― Что представляют собой бактериофаги и чем они могут быть полезны?
― Бактериофаги ― агенты, питающиеся бактериями и способные расщеплять бактериальные клетки в ходе своего жизненного цикла, а если говорить еще проще, то это вирусы, заражающие бактерии. В природе также существуют вирусы, инфицирующие архей, но о них мы сегодня говорить не будем.
В каком-то смысле бактериофагов можно считать независимой формой жизни, главная задача которой ― увеличивать количество собственных копий, распространяться c использованием ресурсов бактериальной клетки-хозяина.
Бактериофаги входят в более широкое понятие, которое обозначают термином «мобильные генетические элементы» (участки хромосом или внехромосомные элементы, способные перемещаться по геному либо создавать собственные копии. ― Примеч. ред.). Фаги представляют собой одну из форм существования таких мобильных генетических элементов. Вне бактериальной клетки они могут защищать свою ДНК при помощи белковой оболочки (капсид). Некоторые из них передаются горизонтально от клетки к клетке, при этом не приводя к их гибели. Существуют также мобильные генетические элементы, которые не самостоятельны: для жизни и распространения они пользуются ресурсами других мобильных генетических элементов и могут паразитировать на фагах. Бактериофаги сами по себе представляют большой интерес для ученых. Кроме того, они могут принести пользу в борьбе с бактериальными инфекциями.
― Где обитают такие вирусы?
― Их можно обнаружить абсолютно везде. Очень сложно назвать какое-то место на планете, где бы их не было. Если мы возьмем океаническую воду, то в 1 мл будет содержаться до 1 млрд фаговых частиц. Даже вездесущих бактерий в природе намного меньше.
Вирусы можно назвать одной из самых успешных форм жизни на Земле, поскольку они превосходят по численности те клетки, на которых паразитируют.
Если говорить об организме человека, то бактериофаги также могут встречаться повсюду, но максмальная их концентрация приходится на кишечник, где, по сути, сформирована полноценная экосистема, стабильный микробиом из бактерий, соседствующий с набором вирусов, метавиромом, которые заражают эти бактерии и поддерживают экологические связи и определенный баланс.
Ученые лаборатории анализа метагеномов Сколтеха совместно с коллегами из МГУ создали самую большую в России коллекцию данных о микробных сообществах окружающей среды. Проект поддержан грантом Минобрнауки РФ. Фото: создано с помощью сервиса «Шедеврум»
― Такого, условно, идеального баланса позволила достигнуть их совместная длительная эволюция? И если в этой системе происходит какой-то сбой, как это может выглядеть?
― Вирусы представляют собой неотъемлемую часть жизни. Если бы речь шла не о Земле, а о какой-то другой планете, то я думаю, что и там обязательно возникли бы паразитические формы, существующие за счет использования ресурсов полноценных клеточных представителей жизни. Вирусы возникают сами по себе в любой системе репликаторов (то есть самокопирующихся молекул). По крайней мере, об этом говорят математические модели исследования репликаторов: все они приводят к вырождению и появлению подобных «персонажей», которые «не хотят» полностью кодировать все нужные ресурсы и «предпочитают» пользоваться ресурсами других, более полноценных форм.
Бактерии и вирусы коэволюционируют несколько миллиардов лет. Это очень длинная история взаимоотношений, она намного дольше, чем время существования многоклеточных форм жизни.
Они в каком-то смысле адаптированы друг к другу и внутри организма человека. Такой баланс тем не менее может быть нарушен при воздействии неблагоприятных внешних факторов. Один из примеров ― знакомый всем коронавирус: переходя к новому хозяину, вирус становится менее контролируемым. Будучи неадаптированным, он может нанести больше вреда, чем требуется для стабильного существования. В долгосрочной перспективе такая стратегия для вируса может быть невыгодной, ведь если вирусы полностью уничтожат все бактерии, на которых они паразитируют, то у них у самих не останется ресурсной базы и они попросту исчезнут. Поэтому вопрос о том, как достигается тот тонкий динамический баланс, когда две враждующие стороны, вирусы и бактерии, хоть и пытаются друг друга уничтожить, в итоге остаются жить вместе, очень интересен. Мы можем предположить, например, что это достигается за счет того, что в организме возникает какое-то разделение на разные экологические ниши. Даже если мы возьмем тот же кишечник, то это не однородная среда.
От местоположения клетки и ее окружения зависит ее состояние и то, как клетка себя «ощущает» и «ведет».
В зависимости от разных факторов клетки могут подстраивать экспрессию своих генов. Таким образом, возникают своеобразные экологические микрониши, когда в одних условиях бактерии более чувствительны к заражению вирусами, а в других условиях ― защищены. Перетекание бактерий из одной формы в другие происходит постоянно. Эти же экологические ниши могут возникать и за счет накопления мутаций: бактерии могут довольно быстро приобрести какие-то мутации, которые сделают их устойчивыми к вирусной инфекции. Но как только вирус исчезнет из среды, эти же мутации могут стать неблагоприятными для бактерий.
― Биомасса бактерий и архей на Земле сравнима с биомассой всех остальных живых существ, а возможно, и значительно превосходит их. Но вирусы по численности опередили даже бактерий?
― Действительно, бактерий на Земле очень много. По биомассе они превосходят вообще всех, но вирусов еще больше. Их геном при этом в среднем в 100 раз меньше генома бактерий, хотя есть и исключения, например вирусы (бактериофаги) под названием джамбофаги. Иногда их геном по размеру крупнее, чем геном некоторых бактерий. Интересно и то, что эти вирусы придумали ядро!
Есть предположение, что ядро в клетках эукариот, к которым относимся и мы с вами, исторически возникло как способ защиты крупных джамбофагов от каких-то клеточных иммунных систем, например определенных ферментов, расщепляющих ДНК.
― То есть изначально ядро впервые на Земле могло появиться именно у вирусов?
― Это спекулятивная тема, требующая подробного изучения, поэтому сказать однозначно сложно, но белки, формирующие ядро у фагов, в чем-то похожи на белки цитоскелета. Джамбофаги в целом недостаточно изучены, потому что исторически ученые работали в лабораториях с теми вирусами, которых проще всего найти и отобрать, чего не скажешь про этих крупных бактериофагов. Некоторые из них не приводят к гибели зараженной клетки, и поэтому они долгое время оставались незамеченными. В основном обращали внимание на самых агрессивных фагов, приводящих к видимому лизису (гибели) бактериальной культуры. Но даже если не брать джамбофагов, то мы не так уж много знаем и о других вирусах.
Когда специалисты обратились к метагеномике и проанализировали метагеном кишечника человека, выяснилось, что о большей части вирусов в кишечнике человека мы вообще ничего до этого момента не знали.
― Можно ли использовать бактериофагов для борьбы с заболеваниями человека?
― Это дискуссионный вопрос. Если коротко, то да. Более длинный ответ ― да, но это очень сложно. Как лекарственное средство фаги сейчас доступны в аптеках, но к их эффективности есть много вопросов. В лабораторных условиях мы всегда можем подобрать такие параметры эксперимента, при которых произойдет гибель любой бактерии от бактериофага. То есть если мы знаем, что в организме человека есть какой-то патоген и именно он ответственен за заболевание, мы можем найти фага, который будет таргетировать конкретно этот патоген, и с большой вероятностью это даже не будет иметь побочных эффектов. Но проблема в том, что разнообразие этих патогенов, вариантов штаммов просто огромное! Я уже говорил, что бактерии все время мутируют. Если мы возьмем, например, знакомую всем кишечную палочку, то у нее есть более 150 вариантов устройства клеточных стенок или капсул, которые эти бактерии продуцируют, или каких-то поверхностных структур. Значит, нужны минимум 150 вирусов, чтобы эффективно таргетировать одну только кишечную палочку. Поэтому часто собираются так называемые фаговые коктейли, когда мы смешиваем много бактериофагов, которые таргетируют циркулирующие в популяции штаммы патогенов. Но мы никогда не сможем дать гарантию, что патоген у данного конкретного пациента будет чувствителен хоть к какому-то из этих фагов. В силу разных причин может появляться устойчивость к ним. В этом плане применять антибиотики гораздо проще: они действуют как ковровая бомбардировка, полностью уничтожая все бактерии, в то время как фаговая терапия ― таргетная и подходит скорее в качестве средства персонализированной медицины, где лечение подбирается индивидуально под каждого пациента.
Тем не менее сегодня мы наблюдаем ренессанс фаговой терапии, который начался около десяти лет назад. Интерес к этому направлению связан с ростом антибиотикорезистентности, наблюдаемым во всем мире. Ученые стали задумываться: может быть, стоит продолжить работы, начатые много лет назад и приостановленные из-за различных сложностей и особой специфики этой области исследований?
― Резистентность бактерий по отношению к вирусам может быть менее сильной, чем в случае с бактериями?
― Нет. Она возникает с такой же частотой, как и в случае с антибиотиками. И причины ее появления очень похожи. В первую очередь это мутации белков-рецепторов, позволяющие сломать интерфейс взаимодействия с вирусом. Из-за такой поломки фаг не сможет узнать бактерию и она станет полностью устойчивой. Появление таких мутантных штаммов практически неизбежно. С другой стороны, такие мутанты могут быть менее приспособлены, и если эта бактерия активно конкурирует за ресурсы с другими бактериями, то она может проиграть. Подобные мутации в большинстве своем невыгодны, а значит, не закрепляются в популяции. Проблема мутаций рецепторов в принципе решаема благодаря использованию смеси фагов, распознающих разные рецепторы. Для этого мы должны четко понимать, какие фаги нами используются, каковы у них специфичность к рецепторам и спектр чувствительности к иммунным системам. Еще одна причина возникновения резистентности бактерий к антибиотикам и вирусам ― появление генов устойчивости, которые передаются горизонтально, то есть от одного штамма бактерии к другому с помощью плазмид (дополнительных факторов наследственности, расположенных в бактериальных клетках вне хромосом и представляющих собой замкнутые или линейные молекулы ДНК. ― Примеч. ред.). Изучение этих генов устойчивости к фагам ― одно из важнейших направлений исследований в нашей лаборатории микробной иммунологии. По сути, это иммунные системы бактерий, и они крайне разнообразны. Мы стали понимать, насколько велико их разнообразие, буквально несколько лет назад. На текущий момент ученым удалось обнаружить более 300 типов таких систем, но я думаю, что это лишь верхушка айсберга. Чтобы фаги работали эффективно, нужно хорошо понимать, как бактерии защищаются от них, так что эта область изучения чрезвычайно важна.
Попадание вирусных частиц на газон бактерий вызвает лизис (гибель бактериальных клеток), что позволяет детектировать бактериофагов в образце и оценивать их количество. Фото: Ольга Мерзлякова / «Научная Россия»
― Вы могли бы привести какой-то пример тяжелого заболевания человека, которое может быть излечено благодаря бактериофагам?
― Например, наследственное хроническое заболевание под названием муковисцидоз, из-за которого в легких накапливается слизь, где затем поселяются бактерии. В результате человек часто погибает от вторичных бактериальных инфекций, хотя само заболевание имеет генетическую природу. При муковисцидозе в мокроте часто обнаруживают синегнойную палочку. Многие ученые по всему миру пытаются избавиться от нее как раз таки с помощью бактериофагов. Недавно на эту тему вышла достаточно качественная научная работа, где был представлен подобный терапевтический подход и были проведены первые клинические испытания на небольшой выборке пациентов. Если специалистам удастся его масштабировать, мы сможем узнать, работают ли фаги в таком формате или нет.
― Возвращаясь к иммунным системам бактерий: в свое время ваша лаборатория была единственной в мире, где занимались изучением одной из таких систем под названием BREX. Эти исследования продолжаются?
― Когда я в 2015 г., будучи студентом магистратуры Сколтеха, начал изучать иммунные системы бактерий (под руководством К.В. Северинова), это направление совершенно не было популярным. В то время с помощью биоинформатики удалось обнаружить первую такую систему, названную BREX. Мы работаем с ней и сегодня. Примечательно, что на самом деле ее открыли еще раньше, в 1980 гг., в СССР. Однако написанные на эту тему статьи не произвели никакого впечатления на мировое научное сообщество, поскольку эти работы были опубликованы не в международных, а в советских журналах. Спустя 30 лет эту тему переоткрыли, что стало очень громким событием в мире биологии. Сейчас тема невероятно популярна. Но для ученого может быть очень полезным найти тему, которой никто пока не занимается.
В нашей сфере конкуренция очень высока, и сегодня, проводя какие-либо исследования, мы, как правило, знаем, что в мире есть как минимум три лаборатории с похожими результатами. И если мы не будем работать достаточно быстро, то наши достижения могут потерять ценность.
― Можно сказать, что на протяжении совместной эволюции у вирусов и бактерий все время происходит гонка вооружений. Как ученым успевать за ней?
― На мой взгляд, эта эволюционная гонка вооружений ― самый интересный вопрос для изучения, и он играет ключевую роль в исследованиях, проводимых в нашей лаборатории. Если у бактерий есть более 300 иммунных систем, значит у вирусов должно быть хотя бы в десять раз больше антииммунных. Фаги коэволюционируют с бактериями, и любое приобретение новой стратегии, позволяющей им выжить, сразу дает сильное преимущество против конкурентов ― как бактерий, так и других фагов. Таким образом, две противоборствующие стороны никогда не могут оставаться неизменными. Стоит одной придумать какую-то новую эффективную стратегию, она тут же приводит к исчезновению отсталого прошлого поколения. Это особенно важно применительно к терапии фагами. Мы могли бы защищать фагов от действий иммунных систем бактерий с помощью модификации их генома и интеграции туда генов, помогающим им заражать бактериальные клетки.
Мне кажется, не стоит надеяться на удачу ― случайный выбор подходящего фага. Мы должны подходить к этой задаче как инженеры. Фаговая терапия сейчас движется к созданию модульных бактериофагов, которых можно было бы собирать, как конструктор.
Когда мы четко понимаем, какие фаговые белки отвечают за распознавание бактериальных клеток (и с какими рецепторами они связаны), мы можем нацелить бактериофага на ту бактерию, которую нам хотелось бы таргетировать в организме. Можно встроить в бактериофага гены защиты от различных иммунных систем бактерий. Если заглянуть совсем в будущее, мы могли бы создавать библиотеки бактериофагов и пользоваться не одним фагом, а иметь в смеси сотни миллиардов частиц, содержащих сразу множество вариантов рецепторов и генов устойчивости к бактериальному иммунитету.
Рост бактерий на специальной индикаторной среде может подсказать, какие процессы происходят внутри клетки. Так, например, появление синего цвета в данном случае говорит о том, что вирусные белки были распознаны системой бактериального противовирусного иммунитета. Фото: Ольга Мерзлякова / «Научная Россия»
― На чем сейчас в большей степени сосредоточен ваш научный интерес?
― Сегодня есть ощущение, что с опорой на мировой научный опыт и глобальное научное сообщество мы в силах решить практически любую задачу в нашей области. Если возникает важный вопрос, то скорее всего рано или поздно будет найден и способ его решения. В изучении бактериального иммунитета активно используются структурные исследования. Мы определяем структуры иммунных и вирусных белков, взаимодействующих с бактериальными клетками и активирующих иммунную систему бактерий. Это позволяет нам понимать атомарное строение наших объектов и детальные механизмы их взаимодействия.
Лично меня всегда интересовали функции неизвестных бактериальных и вирусных генов, так называемая темная материя генома, по аналогии с темной материей космоса, которая не изучена. В биологии складывается похожая ситуация: хорошо изучены на самом деле лишь несколько модельных вирусов, например Т7, лямбда и Т4. Но природное разнообразие вирусов настолько велико, а скорость их эволюции настолько высока, что неизвестными остаются около 80% генов в вирусных геномах. Решение этой проблемы уже приходит с усовершенствованием методов поиска гомологии среди белков, когда благодаря сравнению трехмерной структуры разных, в том числе неизвестных вирусных белков мы можем примерно предсказать, как они должны функционировать.
Священным Граалем лично для меня остается вопрос о том, как вирусы функционируют внутри бактериальной клетки. Пока мы не можем увидеть вживую, как все сложные процессы перехвата управления над бактерией, репликации и синтеза новых вирусных частиц протекают внутри бактериальной клетки на уровне отдельных молекул.
Да, мы моделируем эти системы в лаборатории (выделяем отдельные белки, смотрим, как они взаимодействуют друг с другом и т.д.), но быть всегда уверенными в том, что это именно так работает и в клетке, мы не можем. Я думаю, что глубокое понимание того, как функционирует зараженная вирусом клетка, может стать следующим важным шагом в нашей области исследований.